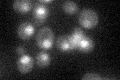
YOR028C
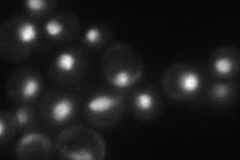
YOR028C
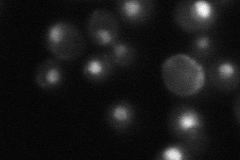
YOR028C
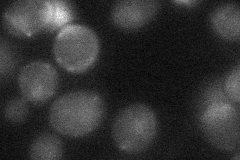
YOR028C
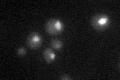
YOR028C

View description
Basic leucine zipper (bZIP) transcription factor of the yAP-1 family, mediates pleiotropic drug resistance and salt tolerance; nuclearly localized under oxidative stress and sequestered in the cytoplasm by Lot6p under reducing conditions
Localization:
Intensity:
Fold change:
Significance:
-
C’ GFP library in SD
nucleus24.27 -
N' NOP1pr-GFP in SD
nucleus45.9159 -
N' TEF2pr-mCherry in SD

nucleusN/A -
N' NATIVEpr-GFP in SD
nucleus34.4438 -
N' TEF2pr-VC and Cyto-VN in SD
nucleus23.4033 -
C’ GFP library in SD+DTT

nucleus19.540.8No -
C’ GFP library in SD+H2O2

nucleus23.780.97No -
C’ GFP library in Starvation Media
nucleus30.951.27No -
C’ GFP library on the background of Pup2-DaMP

nucleus -
C’ GFP library on the background of CCT mutant

nucleus21.15020.871001No
